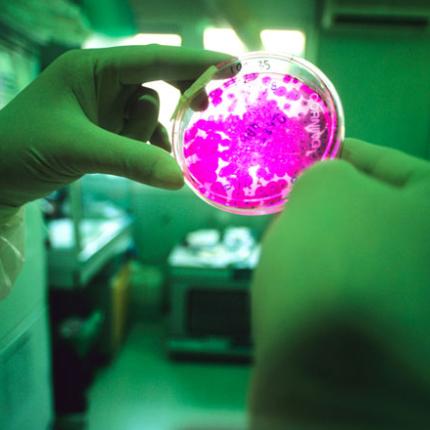
'Εφτιαξαν ανθρώπινο στομάχι με τη βοήθεια βλαστοκυττάρων!

Επιστήμονες στις ΗΠΑ - μεταξύ των οποίων
μία ελληνικής καταγωγής- κατάφεραν για
πρώτη φορά, με τη βοήθεια πολυδύναμων...
ΑΝΑΓΕΝΝΗΤΙΚΗΣ ΙΑΤΡΙΚΗΣ
Body
Αμερικανοί και μεξικανοί επιστήμονες κατάφεραν για πρώτη φορά να δημιουργήσουν στο εργαστήριο γυναικείους κόλπους,...
Ράδιο Κρήτη © | 2013 -2026
ekriti.gr
Όροι Χρήσης
|
Ταυτότητα
Designed by
Cloudevo, developed by
Pixelthis